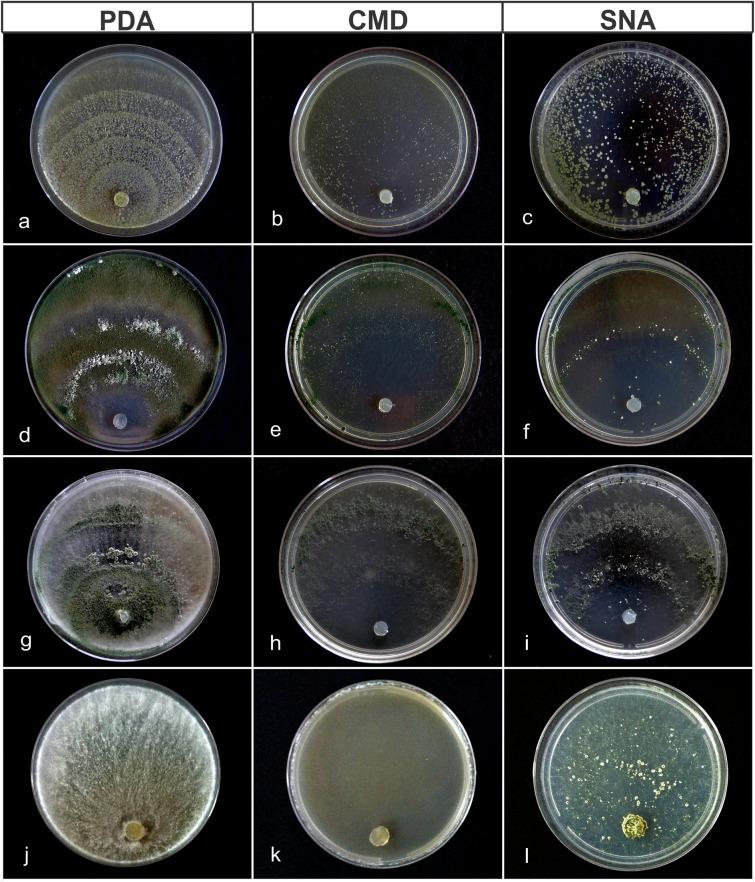
https://cdn.ncbi.nlm.nih.gov/pmc/blobs/2330/7952591/3f0aa0339a35/41598_2021_84111_Fig8_HTML.jpg

从非洲种植和野生咖啡中分离出的作为菌寄生菌和内生菌的拟青霉属新种和记录。
New species and records of Trichoderma isolated as mycoparasites and endophytes from cultivated and wild coffee in Africa.
机构信息
Departamento de Fitopatologia, Universidade Federal de Viçosa, Viçosa, MG, 36570-900, Brazil.
CAB International, Bakeham Lane, Egham, Surrey, TW20 9TY, UK.
出版信息
Sci Rep. 2021 Mar 11;11(1):5671. doi: 10.1038/s41598-021-84111-1.
A survey for species of the genus Trichoderma occurring as endophytes of Coffea, and as mycoparasites of coffee rusts (Hemileia), was undertaken in Africa; concentrating on Cameroon and Ethiopia. Ninety-four isolates of Trichoderma were obtained during this study: 76 as endophytes of healthy leaves, stems and berries and, 18 directly from colonized rust pustules. A phylogenetic analysis of all isolates used a combination of three genes: translation elongation factor-1α (tef1), rpb2 and cal for selected isolates. GCPSR criteria were used for the recognition of species; supported by morphological and cultural characters. The results reveal a previously unrecorded diversity of Trichoderma species endophytic in both wild and cultivated Coffea, and mycoparasitic on Hemileia rusts. Sixteen species were delimited, including four novel taxa which are described herein: T. botryosum, T. caeruloviride, T. lentissimum and T. pseudopyramidale. Two of these new species, T. botryosum and T. pseudopyramidale, constituted over 60% of the total isolations, predominantly from wild C. arabica in Ethiopian cloud forest. In sharp contrast, not a single isolate of Trichoderma was obtained using the same isolation protocol during a survey of coffee in four Brazilian states, suggesting the existence of a 'Trichoderma void' in the endophyte mycobiota of coffee outside of Africa. The potential use of these African Trichoderma isolates in classical biological control, either as endophytic bodyguards-to protect coffee plants from Hemileia vastatrix, the fungus causing coffee leaf rust (CLR)-or to reduce its impact through mycoparasitism, is discussed, with reference to the on-going CLR crisis in Central America.
在非洲进行了一项针对作为咖啡内生菌和咖啡锈病(咖啡叶锈病)真菌寄生菌的拟青霉属物种的调查;重点关注喀麦隆和埃塞俄比亚。在这项研究中获得了 94 株拟青霉属分离物:76 株为健康叶片、茎和浆果的内生菌,18 株直接从定殖的锈病疱中获得。对所有分离物的系统发育分析使用了三个基因的组合:翻译延伸因子 1α(tef1)、rpb2 和 cal,对选定的分离物进行分析。GCPSR 标准用于识别物种;通过形态和文化特征得到支持。结果显示了以前未记录的内生拟青霉属物种多样性,这些物种存在于野生和栽培的咖啡中,并且对咖啡叶锈病具有寄生性。确定了 16 个物种,包括在此处描述的四个新分类群:T. botryosum、T. caeruloviride、T. lentissimum 和 T. pseudopyramidale。这两个新物种,T. botryosum 和 T. pseudopyramidale,占总分离物的 60%以上,主要来自埃塞俄比亚云雾林中的野生 C. arabica。相比之下,在对巴西四个州的咖啡进行的相同分离方案调查中,没有一个拟青霉属分离物被分离出来,这表明在非洲以外的咖啡内生真菌群中存在“拟青霉属空缺”。讨论了这些非洲拟青霉属分离物在经典生物防治中的潜在用途,无论是作为内生菌保镖来保护咖啡植物免受引起咖啡叶锈病(CLR)的咖啡壳球孢菌,还是通过寄生作用来减轻其影响,并参考了中美洲正在发生的 CLR 危机。